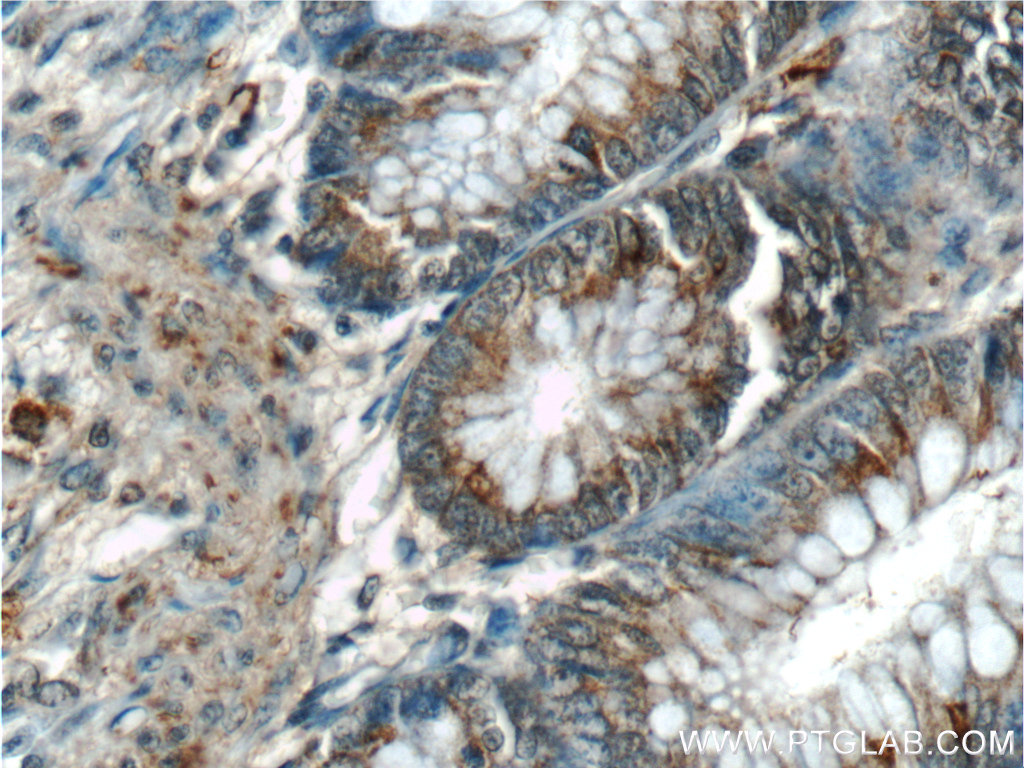

验证数据展示
经过测试的应用
| Positive WB detected in | C2C12 cell, HeLa cells, NIH/3T3 cells, HepG2 cells, C6 cells, K-562 cells |
| Positive IHC detected in | human colon tissue, human oesophagus tissue Note: suggested antigen retrieval with TE buffer pH 9.0; (*) Alternatively, antigen retrieval may be performed with citrate buffer pH 6.0 |
推荐稀释比
| 应用 | 推荐稀释比 |
|---|---|
| Western Blot (WB) | WB : 1:500-1:2000 |
| Immunohistochemistry (IHC) | IHC : 1:50-1:500 |
| It is recommended that this reagent should be titrated in each testing system to obtain optimal results. | |
| Sample-dependent, Check data in validation data gallery. | |
产品信息
55018-1-AP targets Annexin A1 in WB, IHC, IF, ELISA applications and shows reactivity with human, mouse, rat samples.
| 经测试应用 | WB, IHC, ELISA Application Description |
| 文献引用应用 | WB, IHC, IF |
| 经测试反应性 | human, mouse, rat |
| 文献引用反应性 | human, mouse, rat, canine, monkey |
| 免疫原 |
Peptide 种属同源性预测 |
| 宿主/亚型 | Rabbit / IgG |
| 抗体类别 | Polyclonal |
| 产品类型 | Antibody |
| 全称 | annexin A1 |
| 别名 | ANXA1, Annexin 1, Annexin Ac2-26, Annexin I, Annexin-1 |
| 计算分子量 | 40 kDa |
| 观测分子量 | 39 kDa |
| GenBank蛋白编号 | NM_000700 |
| 基因名称 | Annexin A1 |
| Gene ID (NCBI) | 301 |
| RRID | AB_10860266 |
| 偶联类型 | Unconjugated |
| 形式 | Liquid |
| 纯化方式 | Antigen affinity purification |
| UNIPROT ID | P04083 |
| 储存缓冲液 | PBS with 0.02% sodium azide and 50% glycerol, pH 7.3. |
| 储存条件 | Store at -20°C. Stable for one year after shipment. Aliquoting is unnecessary for -20oC storage. |
背景介绍
ANXA1, also named as ANX1, LPC1 and p35, belongs to the annexin family. It is a member of the annexin family of Ca2+-binding and phospholipidbinding proteins, and it is particularly abundant in various populations of peripheral blood leukocytes. ANXA1 regulates phospholipase A2 activity. It seems to bind from two to four calcium ions with high affinity. ANXA1 is a pleiotrophic protein produced by many cell types including peripheral blood leucocytes. The antibody is specific to ANXA1.
实验方案
| Product Specific Protocols | |
|---|---|
| IHC protocol for Annexin A1 antibody 55018-1-AP | Download protocol |
| WB protocol for Annexin A1 antibody 55018-1-AP | Download protocol |
| Standard Protocols | |
|---|---|
| Click here to view our Standard Protocols |
发表文章
| Species | Application | Title |
|---|---|---|
Expert Rev Mol Diagn Co-overexpression of Hsp90-β and annexin A1 with a significantly positive correlation contributes to the diagnosis of lung cancer. | ||
J Cell Sci Platelet-derived microvesicles regulate vascular smooth muscle cell energy metabolism via PRKAA after intimal injury. | ||
J Proteomics iTRAQ-based comparative proteomic analysis of Vero cells infected with virulent and CV777 vaccine strain-like strains of porcine epidemic diarrhea virus. | ||
Mediators Inflamm Interaction between ANXA1 and GATA-3 in Immunosuppression of CD4(+) T Cells. | ||
J Exp Clin Cancer Res Upregulation of Hsp90-beta and annexin A1 correlates with poor survival and lymphatic metastasis in lung cancer patients. | ||
Am J Transl Res Elevated serum annexin A1 as potential diagnostic marker for lung cancer: a retrospective case-control study. |